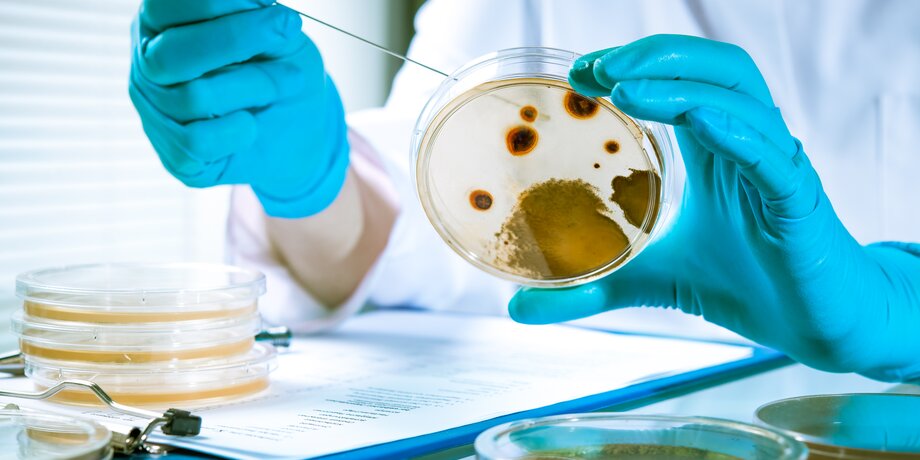

В России набирает силу грипп. Об этом заявила глава Роспотребнадзора Анна Попова. Сейчас в стране циркулируют разные варианты этого вируса. В том числе в регионах выявляют случаи гонконгского гриппа. Рассказываем, какие симптомы он вызывает и как защититься от заболевания.
"Набирает силу"
Среди всех вирусов, которые циркулируют на территории России, растет доля гриппа. Об этом сообщила руководитель Роспотребнадзора Анна Попова. В первую очередь речь идет о гонконгском гриппе (H3N2). Кроме того, регистрируется и свиной (H1N1), но в единичных случаях.
"Сегодня в циркуляции присутствуют все варианты вируса гриппа В, А и H3N2, и это говорит о том, что пока грипп только разгоняется, только набирает силу", – отметила Попова.
Она уточнила, что сейчас еженедельно фиксируется примерно равное количество заразившихся гриппом и прочими ОРВИ: около 700–800 тысяч человек.
По словам Поповой, от гриппа россиян защитит вакцинация. Практически половина населения уже сделала прививку. "У нас иммунная прослойка составляет около 40%, этого еще недостаточно, до конца ноября мы должны закончить прививочную кампанию, но уже сегодня темп показывает, что она позволит защитить население РФ", – объяснила руководитель ведомства.
Ранее три случая гонконгского гриппа зафиксировали в Пермском крае, по одному – в Сахалинской и Орловской областях, по три – в Тюменской и Амурской.
"Штатный" вирус?
Случаи заболевания гонконгским гриппом в РФ не вызывают удивление, он проявлял себя активно и в прошлом году. Об этом в беседе с Москвой 24 заявил иммунолог, кандидат медицинских наук Николай Крючков.
"После 1968 года он начал активно адаптироваться в человеческой популяции. H3N2 – один из представителей обычного гриппа. Поэтому в этом смысле особенно не выделяется. В клинической практике особо не отличим, только за счет лабораторных исследований", – объяснил эксперт.
Эксперт также рассказал о симптомах гонконгского гриппа. "Это ОРВИ-подобные симптомы. К ним относятся повышение температуры больше 38 градусов, боль в горле, кашель. Бывает и насморк, недомогание, боль в мышцах, суставах, общая слабость, бывают желудочно-кишечные проявления (боль в животе и тошнота), головная боль", – перечисляет Крючков.
При тяжелой форме болезни может возникнуть вирусная пневмония, а впоследствии – бактериальная, добавил иммунолог.
Лучшим способом защиты от гриппа Крючков назвал вакцинацию. По его словам, привиться необходимо до конца ноября, поскольку иммунитет формируется на протяжении двух-трех недель после. Тем, кто чувствует недомогание, у кого есть симптомы ОРВИ, рекомендуется оставаться дома или носить и регулярно менять маски.








Сергей Собянин рассказал о строительстве Бирюлевской линии метро